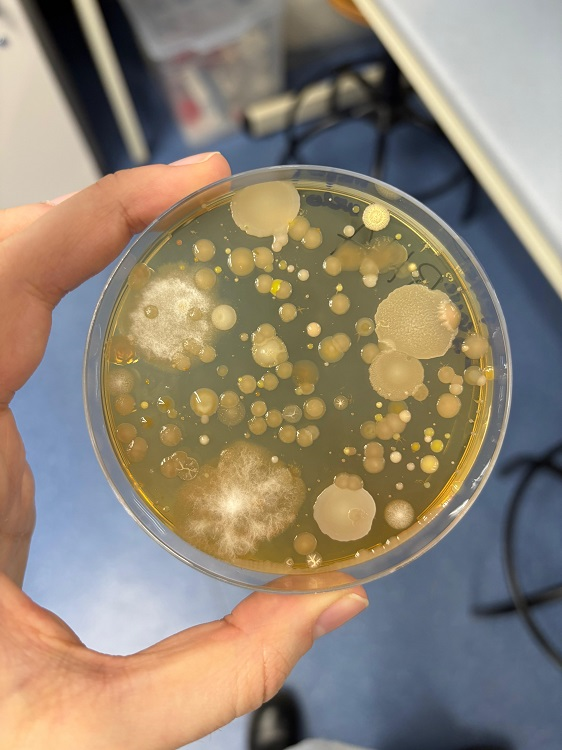

¿Cómo acercamos la ciencia a las nuevas generaciones y creamos conciencia sobre un problema global como la resistencia a los antibióticos? En este nuevo episodio de «Ciencia y Vida», exploramos el increíble proyecto #MicroMundo junto a la Dra. Claudia Parra (Universidad Europea de Madrid).
Descubre cómo estudiantes universitarios se convierten en «profes» por un día para inspirar a jóvenes de secundaria y bachiller en el mundo de la microbiología. ¡Un modelo de #AprendizajeServicio que está marcando la diferencia!
Presentado por la doctora Bárbara Martín-Maldonado.
#Podcast #Ciencia #EducaciónCientífica #ResistenciaAntibióticos #UniversidadEuropea #MicrobiologíaParaJóvenes #Salud #DivulgaciónCientífica
https://enviromicro-journals.onlinelibrary.wiley.com/doi/10.1111/1751-7915.70123